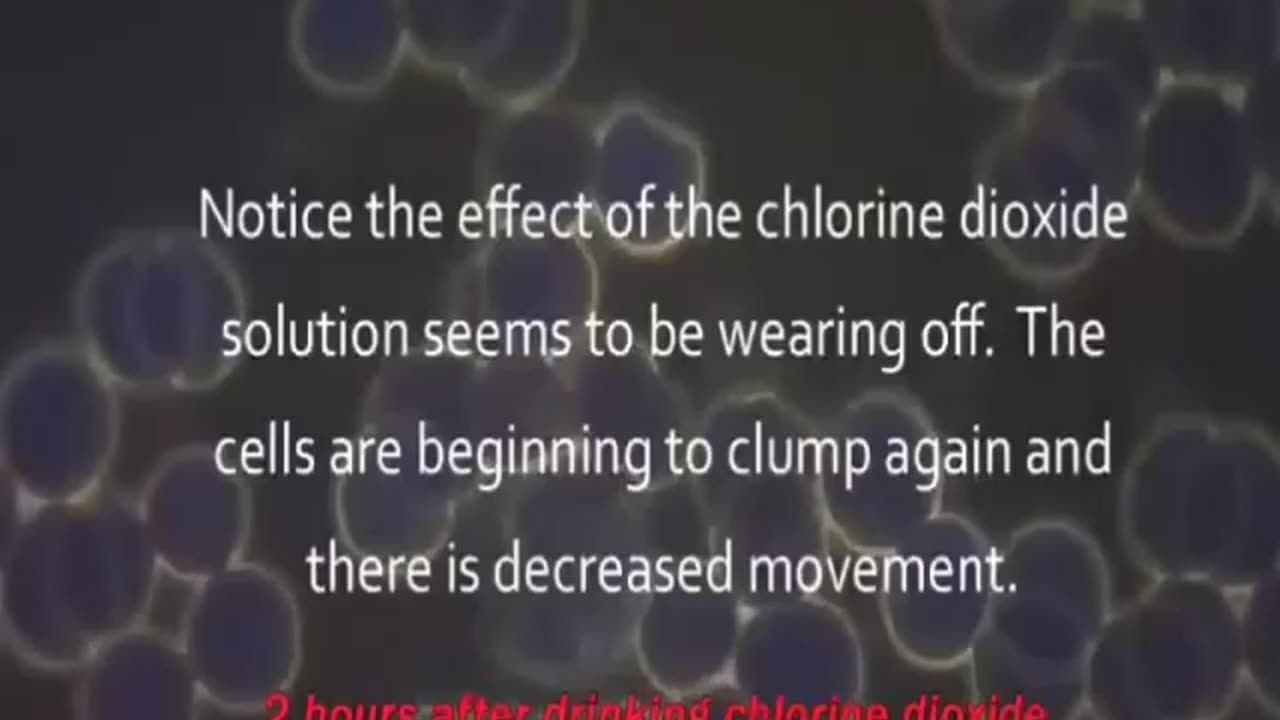
…5 frequencies restore health, cold truth, global warming hoax & digi id the end?

Premium Only Content
…5 frequencies restore health, cold truth, global warming hoax & digi id the end?
If you enjoyed today's video, if you feel you got something from it, there are ways to support this channel. And I thank all those that do.
https://ko-fi.com/ceylon please buy me a coffee.
…5 frequencies restore health, cold truth, global warming hoax & digi id the end?
15.36 cds human blood before & after
20.08 rosemary oikl benefits
23.09 what is cancer
25.39 prostrate cancer cured with cds
28.11 methylene blue uses
30.18 cold truth
31.40 baking soda for energy
32.40 light as medicine
34.09 climate scam 1
36.20 climate scam 2
37.35 global warming hoax
38.19 chemtrails on tv
39.49 gay agenda for afrika
41.00 gender bender
43.03 gender care
44.03 gender consensus is not fact
46.03 eye opening skill.
50.05 diggi id no thanks
51.35 digi id the end
52.42 z fat boy
https://odysee.com/ ceylon
https://www.bitchute.com Ceylon
https://rumble.com/ Ceylon
https://wego.social/ceylon mark ceylon
https://mewe.com mark ceylon
https://www.minds.com/ceylonx ceylonx
https://gettr.com/ ceylonx
…5 frequencies restore health, cold truth, global warming hoax & digi id the end?
-
 12:38
12:38
Timcast
23 hours agoJasmine Crocket HUMILIATED By CNN To HER FACE Over Epstein LIE | Tim Pool
85.5K64 -
 19:32
19:32
MetatronHistory
19 hours agoWas Nazism Left Wing or Right Wing? An Answer From History
9.9K24 -
 LIVE
LIVE
a12cat34dog
3 hours agoI'M FINALLY BACK :: Resident Evil 4 (2023) :: FINISHING MAIN GAME & DLC {18+}
208 watching -
 31:23
31:23
Stephen Gardner
3 hours agoFINALLY! Charlie Kirk MISSING DETAILS released!
17.7K116 -
 5:26:11
5:26:11
cosmicvandenim
8 hours agoCOSMIC VAN DENIM | SEX APPEAL & HORROR
12.5K10 -
 DVR
DVR
DoldrumDan
3 hours agoFINISHING SEKIRO - DEPTH 5 TOP RANKED - DAY 50 NEW LIFE
9.11K1 -
 23:40
23:40
MYLUNCHBREAK CHANNEL PAGE
1 day agoWe Want the Blueprints
60.8K17 -
 LIVE
LIVE
PenguinSteve
5 hours agoLIVE! Penguin to the Battlefield (6)
63 watching -
 1:08:20
1:08:20
The Quartering
6 hours agoMTG Quits, Indian X Meltdown & FBI Caught Lying Again About Trump Assassin
136K72 -
 1:01:33
1:01:33
Jeff Ahern
6 hours ago $10.71 earnedThe Saturday Show with Jeff Ahern
45.9K23